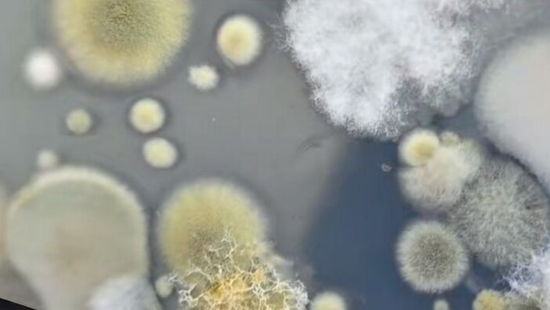

Itt a nagy hó teszt: most kiderül, mennyire tiszta a frissen hullott hó
Újabb érdekes kísérlettel jelentkezett Gyuris Rita.
A férfi épp azt álmodta, hogy húst aprít a családi ebédhez, mikor felébredt a fájdalomra, és meglátta a testét elborító vért.
Sikoltozva ébredt délutáni szunyókálásából egy ghánai farmer: Kofi Atta véletlenül a saját nemi szervét vágta meg egy késsel, miközben azt álmodta, húst darabol. A férfi az egyik heréjét levágta, és a péniszén is megsérült, de az orvosok meg tudták menteni az utóbbit, viszont a 47 éves férfi még további műtétekre szorul – írja a BBC.

Atta a baleset napján délután leült a fotelbe, és elaludt, majd azt álmodta, hogy húst darabol a családi ebédhez. Elmesélése szerint az álom nagyon is valósághű volt, azonban hirtelen felriadt az éles fájdalomra – ekkor vette észre, hogy vérben úszik, és hogy egy kést tart a kezében, amit nem tud, hogyan került hozzá a konyhából. A kiabálására átrohant két szomszédja, de a férfi még így is megpróbált felállni, azonban a fájdalomtól összerogyott. Végül kórházba szállították, ahol azonnal megműtötték. Az orvosok szerint a férfi alva járva sebezte meg magát, és teljesen csak a műtét után kelt fel, mert valójában akkor is aludt, mikor sikoltozni kezdett, vagy mikor megpróbált felállni.
Újabb érdekes kísérlettel jelentkezett Gyuris Rita.

Újabb bejegyzést tett közzé a kormányfő.

Fontos dologra mutatott rá a miniszterelnök.
Nem akar lemaradni a Metropol cikkeiről? Adja meg a nevét és az e-mail címét, és mi hetente három alkalommal elküldjük Önnek a legjobb írásokat!
Feliratkozom a hírlevélrePortfóliónk minőségi tartalmat jelent minden olvasó számára. Egyedülálló elérést, országos lefedettséget és változatos megjelenési lehetőséget biztosít. Folyamatosan keressük az új irányokat és fejlődési lehetőségeket. Ez jövőnk záloga.